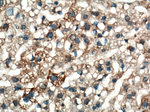
iNOS Antibody in Immunohistochemistry (Paraffin) (IHC (P))

Search
Proteintech
iNOS Polyclonal Antibody
{{$productOrderCtrl.translations['antibody.pdp.commerceCard.promotion.promotions']}}
{{$productOrderCtrl.translations['antibody.pdp.commerceCard.promotion.viewpromo']}}
{{$productOrderCtrl.translations['antibody.pdp.commerceCard.promotion.promocode']}}: {{promo.promoCode}} {{promo.promoTitle}} {{promo.promoDescription}}. {{$productOrderCtrl.translations['antibody.pdp.commerceCard.promotion.learnmore']}}
产品信息
18985-1-AP
种属反应
已发表种属
宿主/亚型
分类
类型
抗原
偶联物
形式
浓度
规格
纯化类型
保存液
内含物
保存条件
运输条件
产品详细信息
This antibody is specific to NOS2.
靶标信息
iNOS (Inducible Nitric oxide, NO, NOS) is an inorganic, gaseous free radical that carries a variety of messages between cells. Vasorelaxation, neurotransmission and cytotoxicity can all be potentiated through cellular response to NO. NO production is mediated by members of the nitric oxide synthase (NOS) family. iNOS is expressed in liver and inducible by a combination of lipopolysaccharide and certain cytokines. NOS catalyzes the oxidization of L-arginine to produce L-citrulline and NO. Two constitutive isoforms, brain or neuronal NOS (b or nNOS, type I) and endothelial cell NOS (eNOS, type III), and one inducible isoform (iNOS, type II), have been cloned. All NOS isoforms contain calmodulin, nicotinamide adenine dinucleotide phosphate (NADPH), flavin adenine dinucleotide (FAD), and flavin mononucleotide (FMN) binding domains. iNOS is found in a variety of cell types including macrophages, hepatocytes, synoviocytes, and smooth muscle cells. Cytokines such as interferon-gamma (IFN), tumor necrosis factor (TNF), interleukin-1 and -2, and lipopolysaccarides (LPS) cause an increase in iNOS mRNA, protein, and activity levels. Protein kinase C-stimulating agents exhibit the same effect on iNOS activity. After cytokine induction, iNOS exhibits a delayed activity response which is then followed by a significant increase in NO production over a long period of time. Three related iNOS pseudogenes are located within the Smith-Magenis syndrome region on chromosome 17. Diseases associated with iNOS dysfunction include achalasia and impotence.
仅用于科研。不用于诊断过程。未经明确授权不得转售。
生物信息学
蛋白别名: calcium-calmodulin independent nitric oxide synthase iNOS; HEP-NOS; Hepatocyte NOS; hepatocytes; inducible nitric oxide synthase; Inducible NO synthase; Inducible NOS; MAC-NOS; Macrophage NOS; nitric oxide synthase; nitric oxide synthase 2, inducible; nitric oxide synthase 2, inducible, macrophage; nitric oxide synthase 2A (inducible, hepatocytes); Nitric oxide synthase, inducible; nitric oxide synthase, macrophage; nitric oxide synthase-inducible; NOS type II; NOS, type II; OTTMUSP00000000202; Peptidyl-cysteine S-nitrosylase NOS2; unnamed protein product
基因别名: HEP-NOS; i-NOS; INOS; Inosl; NOS; Nos-2; NOS-II; NOS2; NOS2A
UniProt ID: (Human) P35228, (Mouse) P29477, (Rat) Q06518
Entrez Gene ID: (Human) 4843, (Mouse) 18126, (Rat) 24599